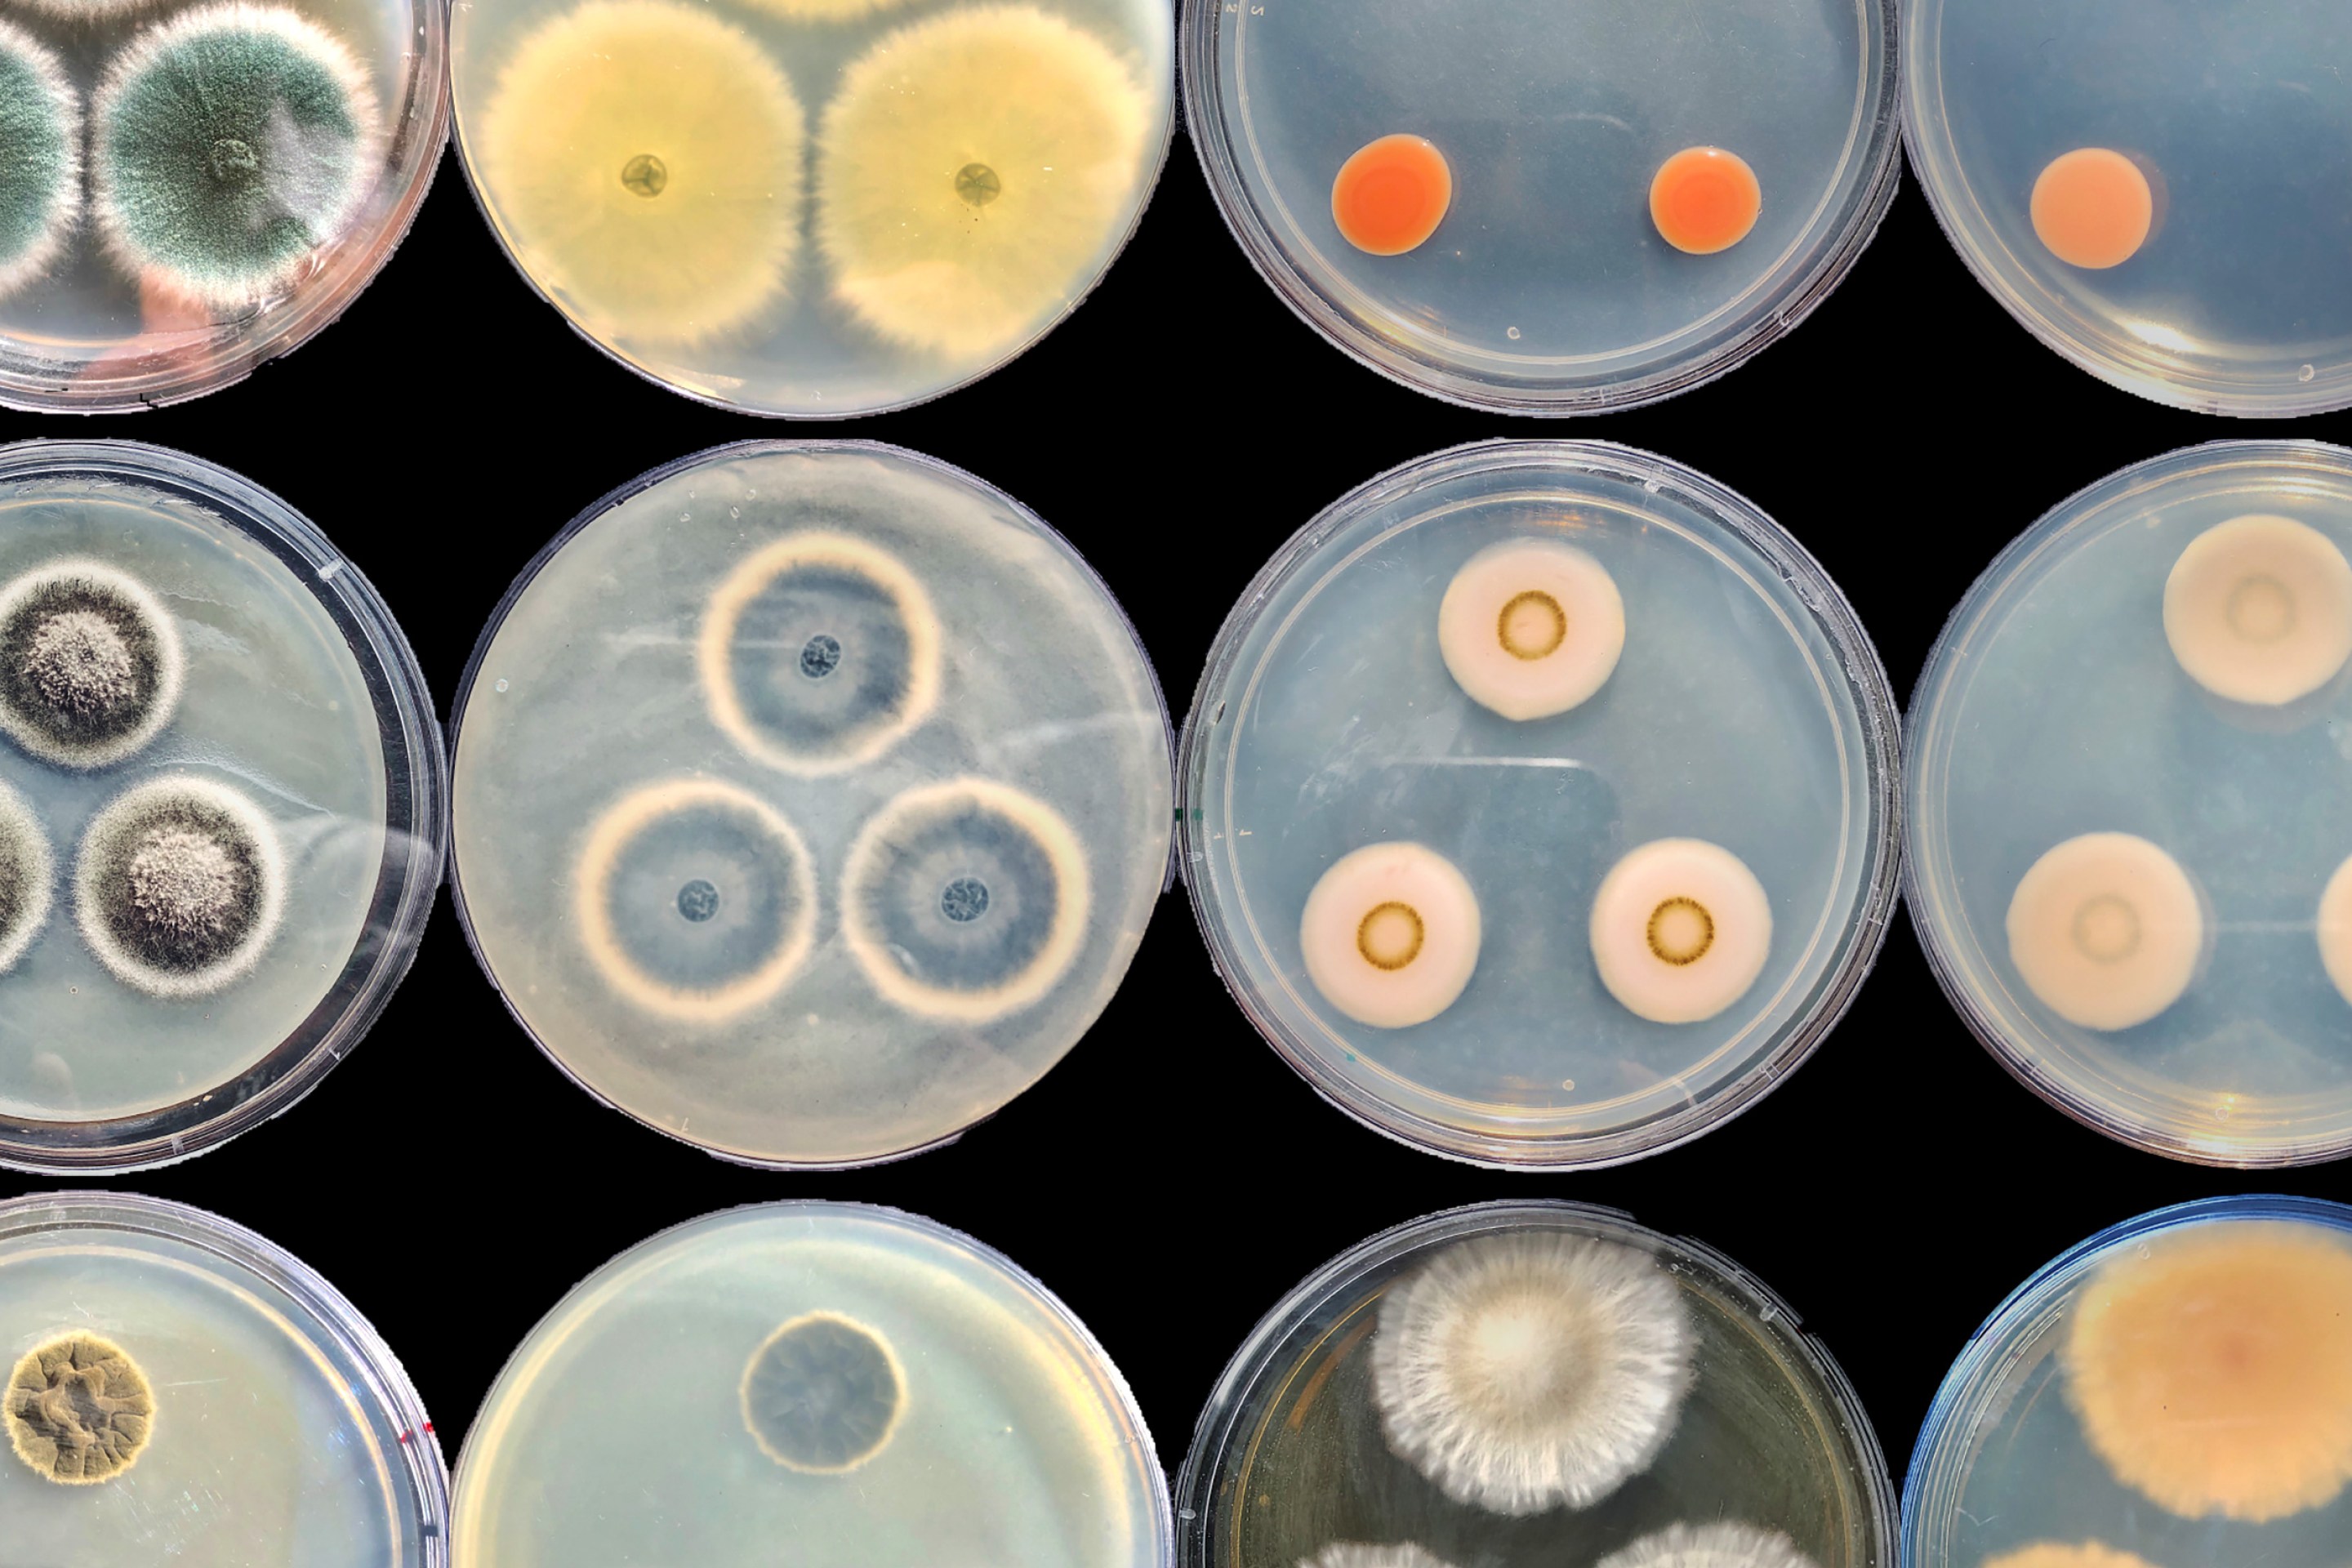

Jordana Cepelewicz
Jordana Cepelewicz is a staff writer at Quanta Magazine.
Math’s “Oldest Problem Ever” Gets a New Answer
A new proof significantly strengthens a decades-old result about the ubiquity of ways to represent whole numbers as sums of fractions.
DNA Has Four Bases. Some Viruses Swap in a Fifth.
The DNA of some viruses doesn’t use the same four nucleotide bases found in all other life. New work shows how this exception is possible and hints that it could be more common than we think.
Nobel Chemistry Prize Awarded for CRISPR ‘Genetic Scissors’
Emmanuelle Charpentier and Jennifer Doudna have been awarded the 2020 Nobel Prize in Chemistry for their development of CRISPR/Cas9 genetic editing.
Scientists Win Nobel Prize for Discovering the Hepatitis C Virus
Harvey Alter, Michael Houghton and Charles Rice were awarded the 2020 Nobel Prize in Physiology or Medicine for their discovery of the cause of a major liver disease.
Reasons Revealed for the Brain’s Elastic Sense of Time
Research finds that the subjective experience of time is linked to learning, thwarted expectations and neural fatigue.
‘Zombie’ Microbes Redefine Life’s Energy Limits
A new model shows that the denizens of a vast, ancient biome beneath the seafloor use barely enough energy to stay alive—and broadens understanding of what life can look like.
Out-of-Sync ‘Loners’ May Secretly Protect Orderly Swarms
Studies of collective behavior usually focus on how crowds of organisms coordinate their actions. But what if the individuals that don’t participate have just as much to tell us?
Sugary Camouflage on Coronavirus Offers Vaccine Clues
In the fight against viruses and other pathogens, scientists are looking beyond genes and proteins to the complex sugars, or glycans, on cell surfaces.
In Brain Waves, Scientists See Neurons Juggle Possible Futures
Faced with a decision, the brain weighs its options by bundling them into rapidly alternating cycles of brain waves.
New Clues About ‘Ambigram’ Viruses With Strange Reversible Genes
For decades, scientists have been intrigued by tiny viruses whose genetic material can be read both forward and backward. New research begins to explain this puzzling property.
Nobel Prize Awarded for Discoveries on How Cells Adapt to Oxygen
The 2019 Nobel Prize in Physiology or Medicine honors work elucidating how cells adjust to low oxygen levels.
Your Brain Chooses What to Let You See
Beneath our awareness, the brain lets certain kinds of stimuli automatically capture our attention by lowering the priority of the rest.